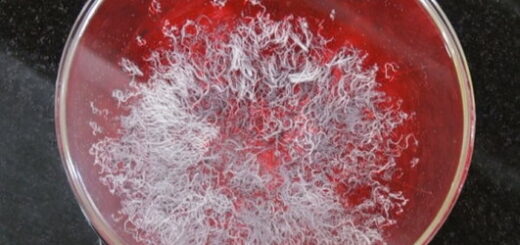

我終於見到 「菩提道損減增益法」 殊勝無上

我終於見到 「菩提道損減增益法」 殊勝無上
當我聽到有一位太尊級的巨聖要來本寺修「菩提道損減增益法」,我們以至誠的心做好了迎接的準備。太尊屬於五段金釦,他的本事真有這麼大嗎? 這社會已真相混亂,公說公有理,婆說婆有理,假的可以冒真,騙人鬼話一大堆。尤其是有一個法王把我嚇怕了,他哪裡是名大法王,就是一個欺世釣名的凡夫而已,提到他的名字都反噁!自己明明是凡夫俗子的質地,卻狂妄聲稱要教人成聖者,他的言行低劣可悲,完全不符事實,他的出現,告訴了人們假的都可以冒充真的,沒有所謂的真跟假,只有胡說八道,騙一事算一事。你們看看他到底是聖者還是凡夫的言行。你們認為聖者會不會把八竿子打不到的事,與他沒有私毫關係的事拉到自己的身上,藉用與他無關的事來為自己宣傳造勢,聖者會幹這樣下濁的事嗎?只有凡夫俗子才會幹出見好處、見名譽就沾的事,難道不是這樣嗎?大家都有頭腦可以想一想,做為一個真正的聖者,他們根本不會去沾染世俗名譽,更何況這件事與他一點關係都沒有,還要強行拿來為自己說話,這樣的人是凡夫還是聖者呢?大家自己想吧!當然,太尊的地位比法王的地位要高太多了,人家是聖量真才實料考來的,法王只是凡夫認證的空洞無實的名詞,儘管太尊的地位高,我畢竟沒有實際看過太尊修法。昨天,五月十四日,因緣成熟了,這位大摩訶薩五段金釦太尊,我們又稱他為聖尊,他在世界佛教總部與我們僧眾一起共同開法會,公開為一位十分虔誠做佛事的弟子舉行了主旨為「菩提道損減增益法」,讓我開了聖界之眼,除了驚嘆,餘下的就是五體投地和深深的懺悔。原來,「菩提道損減增益法」真是無上大法之大法,我一直都盼望能參加這個法會,今天終於參加了這場萬劫千身難遇的大法會,當機會來了我怎麼會放過每一秒鐘,到底有多厲害的聖境,因此,我選了最近約四呎遠的位置觀看,我兩眼瞪大不放過分毫機會,我們所有的人都盯住了,被加持的弟子一顆一顆的點數菩提丸,把十顆菩提丸放在瓷器的杯子裡,然後修法的聖尊站在遠處,沒有任何人接近過杯子。修法時,突然杯子慢慢放光,聞到了異香撲鼻,隨著一聲鐘響,聲音與平常完全不同,好像在風浪中滾動,整個大殿迴盪著吉祥的氣氛,懾人心靈,我眼前只看到杯子,這時大殿及供品等都不見了,我好像坐在軟棉的空氣上,人感覺在旋轉,但杯子沒有離開我的眼睛,此時萬念俱寂沒有任何動靜,杯子裡的菩提丸突然長出了三顆,太神妙了,再次點數,確實由十顆增長到了十三顆。這位受法弟子的真誠換來了如此勝義的福報,從此以後,她持有的菩提丸不斷增加,她可以每月吃一顆或每天吃一顆,確保長壽無病,福慧圓滿,得到成就。最值得讚嘆的是聖尊如此道行高深,而身上沒有半點我執貪名的氣息。聖尊對我們說:「菩提丸修了就修了,這都是佛菩薩加持的,不是我修成的,不要提到我,誰要提到我的法號,今後我主持的法你們就沒份了。我們都是佛弟子,重要的是學佛修行,不是拿名來招搖。」,並對受法弟子說:「我要一顆菩提丸貢獻給我的恩師,南無第三世多杰羌佛,祝福明天佛誕,吉祥永樂。」 聖尊的遠離名譽地位,比起那凡夫虛名的假聖法王是天差地別的,超凡的聖品是我們學習的楷模,也是我懺悔的醒鐘,我現對十方諸佛發下重誓,一定如法修行,自覺覺他。
慚愧佛弟子
釋了正
2021年5月15日
本文鏈接:https://truebuddhanet.com/我終於見到-菩提道損減增益法-殊勝無上/